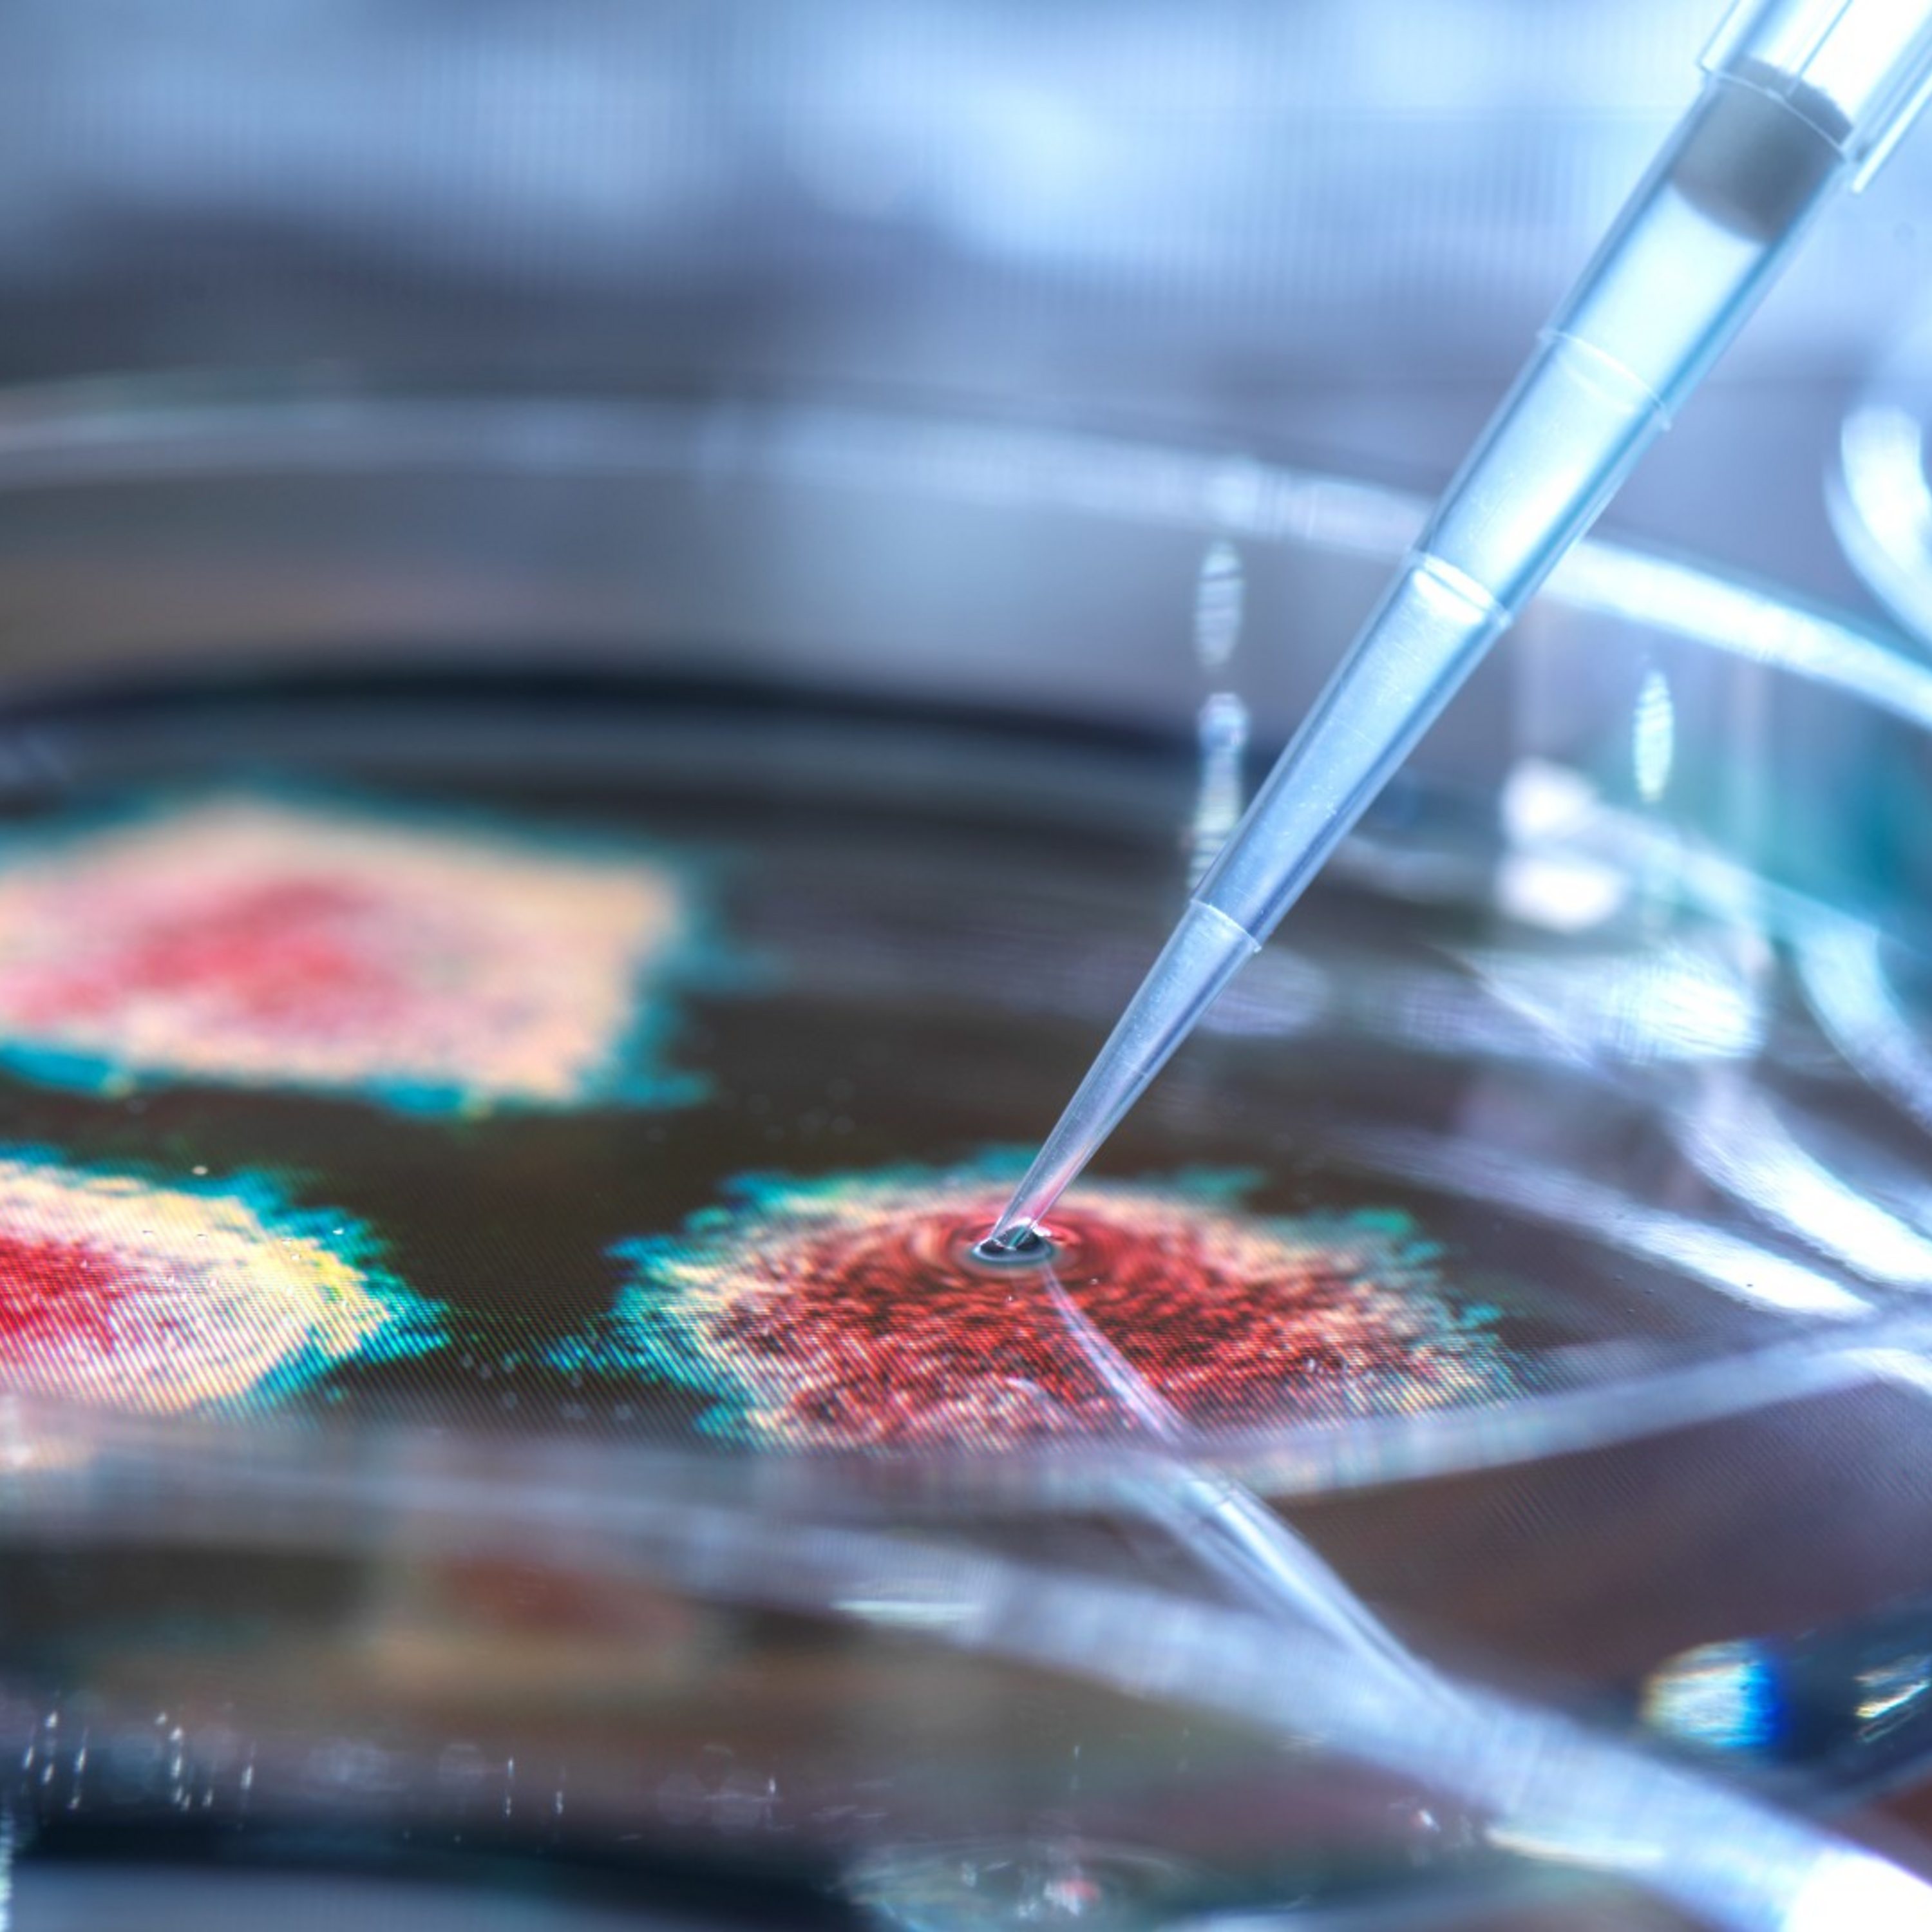

- Other
- SEE MORE
- classical
- general
- talk
- News
- Family
- Bürgerfunk
- pop
- Islam
- soul
- jazz
- Comedy
- humor
- wissenschaft
- opera
- baroque
- gesellschaft
- theater
- Local
- alternative
- electro
- rock
- rap
- lifestyle
- Music
- como
- RNE
- ballads
- greek
- Buddhism
- deportes
- christian
- Technology
- piano
- djs
- Dance
- dutch
- flamenco
- social
- hope
- christian rock
- academia
- afrique
- Business
- musique
- ελληνική-μουσική
- religion
- World radio
- Zarzuela
- travel
- World
- NFL
- media
- Art
- public
- Sports
- Gospel
- st.
- baptist
- Leisure
- Kids & Family
- musical
- club
- Culture
- Health & Fitness
- True Crime
- Fiction
- children
- Society & Culture
- TV & Film
- gold
- kunst
- música
- gay
- Natural
- a
- francais
- bach
- economics
- kultur
- evangelical
- tech
- Opinion
- Government
- gaming
- College
- technik
- History
- Jesus
- Health
- movies
- radio
- services
- Church
- podcast
- Education
- international
- Transportation
- kids
- podcasts
- philadelphia
- Noticias
- love
- sport
- Salud
- film
- and
- 4chan
- Disco
- Stories
- fashion
- Arts
- interviews
- hardstyle
- entertainment
- humour
- medieval
- literature
- alma
- Cultura
- video
- TV
- Science
- en
Could Covid-19 have come from a lab leak?
For the last year discussions about the origins of Covid-19 have divided people all over the world. Some say it came from nature and others believe it could have escaped from a lab. The idea of a lab accident was originally dismissed as a conspiracy theory but it\u2019s starting to gain attention all over again.
Now President Biden has given the US intelligence service 90 days to try and investigate the virus's origins further.
Many still believe the virus jumped to humans from animals but some say that we need to be open minded until we have all of the data.
But could Covid-19 really have come from a lab?
Presenter: Kavita Puri\nProducer: Olivia Noon\nResearcher: Kirsteen Knight
(Virus research in a lab. Tek Science/Getty images)